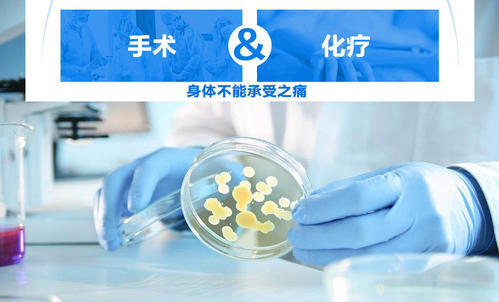

正常的卵巢功能是女人生育的基础,也是女性青春的保鲜剂!所以对于女性来讲,听到卵巢早衰几个字就犹如“谈虎色变”!
卵巢早衰是指妇女在初潮以后到40岁以前由于卵巢功能衰退而引起月经失调、性欲减退、性功能降低、不孕、围绝经期综合征等一系列症状的健康问题。
其特征是卵巢内无卵母细胞或虽有原始卵泡,但对促性腺激素无反应,表现为低雌激素和高促性腺激素状态。
卵巢早衰让年轻女人不再“年轻”。
而生活中有不少的行为是造成卵巢早衰的罪魁祸首,却往往被大家所忽视。下面就看看这些造成卵巢早衰的行为,你知道几个吧!
1
频繁做人流
人工流产术是女性避孕失败的一种补救措施,做一两次一般不会有太严重的并发症,但是那些把流产当作“万能避孕措施”的人,只能说实在是没有自我保护意识。



反复做人流会人为的中断妊娠,会使因怀孕而升高的体内雌激素、孕激素水平急剧下降,造成下丘脑一垂体一卵巢轴调节紊乱,可导致月经不调,甚至闭经,造成卵巢早衰,如果造成永久性闭经,可能这辈子都“没机会”再做人流。
2
吸烟
“男人吸烟伤肺伤精,女人吸烟伤卵巢”这话绝不是危言耸听,是赤裸裸的事实。



香烟中的尼古丁、镉和多环芳烃类物质可使女性卵巢受到毒害,使成熟的卵母细胞减少;同时对卵巢雌激素合成过程中的芳香化酶有特异性的抑制作用,使雌激素的生成减少,进而引起月经紊乱,甚至闭经,进一步发展为卵巢早衰。
3
不良情绪
不良的情绪可使体内的免疫活性物质分泌减少。强烈的情绪波动或突然巨大的精神刺激可使中枢神经系统改变,形成负性条件反射,导致下丘脑FSH、LH及卵巢激素分泌异常,内分泌紊乱,改变了月经周期,最终发展为卵巢早衰。



4
劣质染发剂、化妆品
染发剂,增白化妆品,尤其是劣质品中所含有的苯、汞化合物,可以通过皮肤粘膜吸收,导致女性卵巢功能严重受损。
许多环境中的毒物如橡胶制品、杀虫剂、塑料制品抗氧化剂代谢物4-乙烯环己烯等会危害人类生殖功能,引起卵巢功能减退。
5
新装修的房子
室内装修后含有对人体危害较大的有毒物质主要有甲醛、苯、氨、氧等这些有害物质对女性生殖系统的损害主要是引起月经紊乱。当室内空气中游离甲醛浓度异常升高时,40%以上的女性出现月经周期不规律、经期延长或月经量减少。



6
放射线
放射线损害卵巢的主要变化是卵泡丧失,间质纤维化和玻璃样变,血管硬化和门细胞储留等。



因工作、疾病或意外事故接受大剂量或长时期的放射线(放疗),可破坏卵巢引起卵巢早衰。
7
化疗
化疗药物对卵巢功能的影响与患者年龄、用药方法、药物种类及用药时间等密切相关,烷化剂较易引起卵巢早衰。

化疗可致卵巢包膜增厚、间质纤维化,但卵巢内存在大量停止发育的卵泡,因此化疗药物停用后,65%~70%的患者可以恢复卵巢的正常功能。越年轻的患者化疗后卵巢功能恢复的可能性越大。年轻女性化疗期间的卵巢保护治疗是必不可少的。
8
长期服用紧急避孕药
紧急避孕药的主要成分是左炔诺孕酮,避孕的机制为:在排卵期服药,能使子宫内膜发育出现不利于受精卵着床的改变;排卵前服药,可以延迟排卵;黄体期服药,可以影响黄体功能,不利于妊娠的继续。



紧急避孕药只能在避孕措施失败后临时补救,不能作为常规避孕药来避孕,服用一次,相当于常规避孕药的10倍,对女性身体伤害很大,长期服用,势必会影响卵巢功能,原因是孕激素对雌激素具有拮抗作用,若长期大剂量的补充孕激素,会导致雌激素水平下降,对下丘脑和垂体的抑制作用解除,引起FSH、LH的升高,导致卵巢早衰的发生。
9
睡眠障碍
在当代快节奏、高压力的竞争环境中,睡眠障碍已经成为大部分女性的一个普遍症状,这与性激素水平尤其是雌激素水平的下降有着很大的关系。雌激素能够使睡眠潜伏期缩短,入睡后觉醒次数减少,增加总睡眠时间。
入睡后人体体温下降,而雌激素可以参与体温调节,若雌激素水平降低可能会改变体温调节过程,使昼夜节律发生变化,从而影响睡眠质量。



5-羟色胺具有催眠的作用,雌激素能够增加5-羟色胺的合成,雌激素水平下降使其合成减少,睡眠质量下降。反过来,存在睡眠障碍的女性会影响雌激素合成和释放的时间周期性,影响卵巢功能,长期的失眠便为卵巢早衰埋下隐患。
10
腹部手术
卵巢周围组织手术可能损伤卵巢血液供应引起卵巢早衰,诸如子宫切除术、输卵管结扎或切除、子宫内膜异位症的保守或半根治手术,输尿管盆腔段手术、卵巢肿瘤剥除术或一侧卵巢切除术等。



术后1-5年是卵巢功能减退的高发期,术后残留正常卵巢组织过少和术中损伤较大血管是卵巢保守性手术后发生卵巢早衰的主要原因。另外,腹腔镜下对卵巢剥离面进行直接电凝止血可能造成卵巢储备功能低下,且双极电凝会损伤卵巢皮质。
原因是电凝是利用高频电流对手术区域组织产生热效应,使组织细胞坏死、变性、干燥、气化、碳化,以达到止血和分离的作用。若创面大,反复过度的电灼会导致残留卵巢皮质的损伤,破坏残留的卵泡及皮质的血供,影响术后卵巢储备功能。
